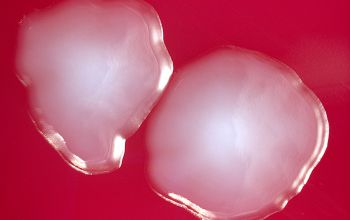

Shigella flexneri
-
General information
Taxonomy
Family: Enterobacteriaceae
There are 4 subgroups of Shigella
- S. dysenteriaea
- S. flexneri
- S. boydii
- S. sonnei
The primary difference between E. coli and Shigella is the ability of Shigella to invade the intestinal epithelium.
Natural habitats
Humans and other large primates are the only natural reservoirs of Shigella bacteria.
Most transmission is by person-to-person spread, but infection is also caused by ingestion of contaminated food or water.
Shigellosis is most common in situations in which hygiene is compromised (e.g., child care centers, and other institutional settings).
In developing populations without running water and indoor plumbing, shigellosis can become endemic.
Sexual transmission of Shigella among men who have sex with men also occurs.
Clinical significance
They are the causative agents of bacillary dysentery.
Shigella causes bloody diarrhea (dysentery) and non-bloody diarrhea.
Shigellosis often begins with watery diarrhea accompanied by fever and abdominal cramps but may progress to classic dysentery with scant stool containing blood, mucus and pus.
Ulceration, which are restricted to the large intestine and rectum, typically do not penetrate beyond the lamina propria.
Bloodstream infections can occur but are rare.
All 4 subgroups of Shigella are capable of causing dysentery.
S. dysenteriae serotype 1, is associated with the most severe form of dysentery.
-
Gram stain
Gram negative rods
-
Culture characteristics
-
Facultative anaerobic
Selective media for the isolation of Salmonella and Shigella from clinical specimens
XLD / xylose lysine desoxycholate agar
Shigella cannot ferment xylose ► red colonies
Enterobacteriaceae ferment xylose ► yellow colonies
HEK / hektoen agar
These bacteria grow with green to blue-green colonies on the agar.
BA: colonies are small, circular, translucent, domed after 24 hours.
McConkey: colonies are pale, non lactose fermenter
BBAØ: growth
-
-
Characteristics
-
References
James Versalovic et al.(2011) Manual of Clinical Microbiology 10th Edition
Karen C. Carrol et al (2019) Manual of Clinical Microbiology, 12th Edition